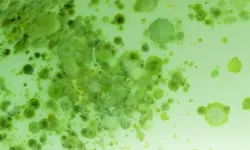
Jesucristo advirtió que, antes de su regreso, "habrá pestes, y hambres, y terremotos en diferentes lugares. Y todo esto será principio de dolores".

Las Buenas Noticias: Mayo - Junio 2020
En ésta edición de Las Buenas Noticias ofrecemos información sobre las posibles consecuencias y lo que el nuevo Coronavirus significa desde una perspectiva bíblica. También un interesante artículo acerca del Espíritu Santo de Dios y su poder transformador en nuestras vidas.
Tabla de contenido
playlist